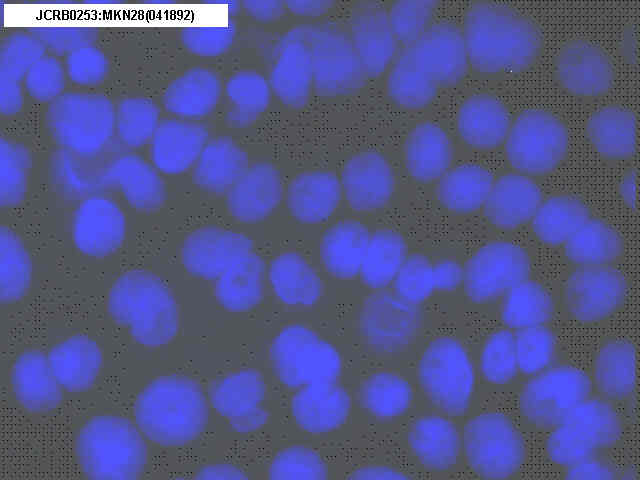

JCRB0253 MKN28
Cell information
Important Notice(s)JCRB0253 MKN28 is derived from MKN74.
The problem in the identity of MKN28 cell line
Cell type:general cells (View Pricing Information)
| JCRB No. | JCRB0253 | Cell Name | MKN28 |
|---|---|---|---|
| Profile | Stop providing for the issue of quality control. (Please contact us for more information) STR-PCR analysis indicated the MKN28 is derived from MKN74. | Other Name | MKN28 |
| Animal | human | Strain | |
| Genus | Homo | Species | sapiens |
| Sex | Age | ||
| Identity | available | Tissue for Primary Cancer | stomach |
| Case history | Metastasis | ||
| Tissue Metastasized | Genetics | stomach, 70 year-old female. | |
| Life Span | Crisis PDL | ||
| Morphology | Character | stomach, 70 year-old female. | |
| Classify | Established by | Hojo,H. | |
| Registered by | Motoyama & Watanabe | Regulation for Distribution | |
| Comment | Moderately differentiated tubular adenocarcinoma. Mycoplasma-eliminated cells by MC-210. | Year | 1989 |
| Medium | RPMI1640 medium with 10% fetal calf serum | Methods for Passages | Cells are treated with 0.02 % EDTA and 0.25% trypsin. |
| Cell Number on Passage | split ratio=1/10-1/20 | Race | |
| CO2 Conc. | 5 % | Tissue Sampling | stomach |
| Tissue Type |
| Detection of virus genome fragment by Real-time PCR | |||||||||
|---|---|---|---|---|---|---|---|---|---|
| Detected DNA Virus | not tested | Detected RNA Virus | not tested | ||||||
| Reference | |
|---|---|
| Pubmed id:2736210 | Production of transforming growth factor-alpha in human tumour cell lines. Imanishi K,Yamaguchi K,Suzuki M,Honda S,Yanaihara N,Abe K Br J Cancer. 1989 May;59(5):761-5 |
| Pubmed id:3095279 | Detection of amplified DNA sequences in gastric cancers by a DNA renaturation method in gel. Nakatani H,Tahara E,Yoshida T,Sakamoto H,Suzuki T,Watanabe H,Sekiguchi M,Kaneko Y,Sakurai M,Terada M Jpn J Cancer Res. 1986 Sep;77(9):849-53 |
| Pubmed id:3962675 | Comparison of seven cell lines derived from human gastric carcinomas. Motoyama T,Hojo H,Watanabe H Acta Pathol Jpn. 1986 Jan;36(1):65-83 |
| Images |
|---|
![]() ![]() ![]() ![]() ![]() ![]() ![]() ![]() ![]() ![]() ![]() ![]() |
LOT Information
Viability/Growth rate/Cell number are represented as actual values measured at lot presentation in JCRB, but are not guaranteed values. Additionally, the doubling time is a rough value measured during passages.| Cell No. | JCRB0253 | Cell Name | |
|---|---|---|---|
| LOT No. | 09012009 | Lot Specification | distribution |
| Medium | RPMI 1640 medium with 10% fetal bovine serum (GIBCO Cat. # 10099) | Temperature | 37 C |
| Cell Density at Seeding | approx. 1 x 10^5 cells/ml | Methods for Passages | Cells were harvested aftert treatment with 0.25% trypsin and 0.02% EDTA. |
| Doubling Time | approx. 29 hrs. | Cell Number in Vial (cells/1ml) | 1.0 x 10^7 |
| Viability at cell freezing (%) | 91.3 | Antibiotics Used | free |
| Passage Number | P24 | PDL | |
| Sterility: MYCOPLASMA | - | Sterility: BACTERIA | - |
| Sterility: FUNGI | - | Isozyme Analysis | Confirmed as human by NP, G6PD (type B), MD. |
| Chromosome Mode | Chromosome Information | ||
| Surface Antigen | DNA Profile (STR) | ||
| Adhesion | Yes | Exoteric Gene | |
| Medium for Freezing | 10% DMSO, 20% FBS - RPMI 1640 | CO2 Conc. | 5% |
| Viability immediately after thawing (%) | Additional information |
| Cell No. | JCRB0253 | Cell Name | MKN28 |
|---|---|---|---|
| LOT No. | 081495 | Lot Specification | distribution |
| Medium | RPMI1640 medium with 10% fetal bovine serum (JRH.12103-78) | Temperature | 37 C |
| Cell Density at Seeding | 5.6x10^4 cells/ml | Methods for Passages | Treat cells with 0.25% trypsin and 0.02% EDTA. |
| Doubling Time | NT | Cell Number in Vial (cells/1ml) | 1.5x10^6 |
| Viability at cell freezing (%) | 97.5 | Antibiotics Used | free |
| Passage Number | P18 | PDL | NT |
| Sterility: MYCOPLASMA | - | Sterility: BACTERIA | - |
| Sterility: FUNGI | - | Isozyme Analysis | NT |
| Chromosome Mode | NT | Chromosome Information | NT |
| Surface Antigen | NT | DNA Profile (STR) | |
| Adhesion | Yes | Exoteric Gene | NT |
| Medium for Freezing | CO2 Conc. | ||
| Viability immediately after thawing (%) | Additional information |
| Images |
|---|
![]() ![]() |
| Cell No. | JCRB0253 | Cell Name | MKN28 |
|---|---|---|---|
| LOT No. | 022289 | Lot Specification | distribution |
| Medium | RPMI 1640 + FCS 10% | Temperature | 37 |
| Cell Density at Seeding | 1/10-1/20 | Methods for Passages | 0.01% EDTA and 0.25% trypsin. |
| Doubling Time | NT | Cell Number in Vial (cells/1ml) | 3x10^6 |
| Viability at cell freezing (%) | 85% | Antibiotics Used | free |
| Passage Number | P14* | PDL | |
| Sterility: MYCOPLASMA | - | Sterility: BACTERIA | - |
| Sterility: FUNGI | - | Isozyme Analysis | LD,G6PD,NP,PepB,AST,MD |
| Chromosome Mode | Chromosome Information | NT | |
| Surface Antigen | DNA Profile (STR) | ||
| Adhesion | Exoteric Gene | ||
| Medium for Freezing | CO2 Conc. | ||
| Viability immediately after thawing (%) | Additional information |
| Cell No. | JCRB0253 | Cell Name | |
|---|---|---|---|
| LOT No. | 022698 | Lot Specification | distribution |
| Medium | RPMI1640 medium with 10% fetal calf serum (FCS lot; BioWhittaker 6M0121) | Temperature | 37 C |
| Cell Density at Seeding | 1-3 x 10^5 cells/ml | Methods for Passages | 0.25% trypsin and 0.02% EDTA |
| Doubling Time | Cell Number in Vial (cells/1ml) | 2.0 x 10^6 | |
| Viability at cell freezing (%) | 93.0 | Antibiotics Used | free |
| Passage Number | P3* | PDL | |
| Sterility: MYCOPLASMA | - | Sterility: BACTERIA | - |
| Sterility: FUNGI | - | Isozyme Analysis | Confirmed as human by NP, G6PD (type B), LD. |
| Chromosome Mode | Chromosome Information | ||
| Surface Antigen | DNA Profile (STR) | ||
| Adhesion | Exoteric Gene | ||
| Medium for Freezing | CO2 Conc. | ||
| Viability immediately after thawing (%) | Additional information |